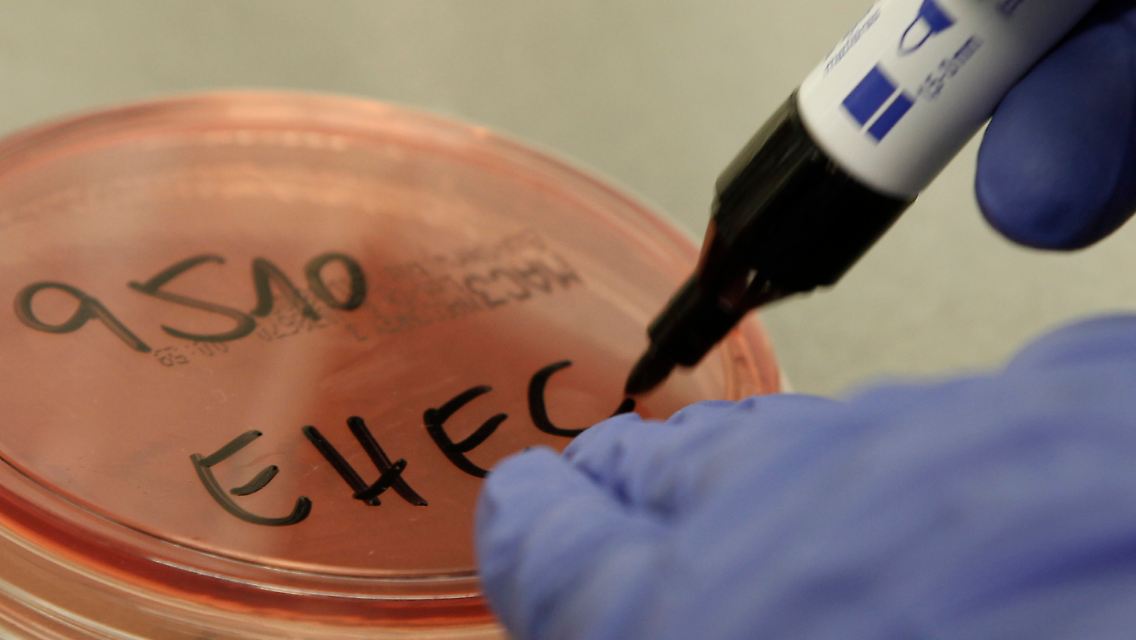

Verdachtsfälle steigen sprunghaft an Erste Tote mit EHEC-Infektion
24.05.2011, 15:33 UhrBis zu drei Menschen sind bisher an einer EHEC-Infektion gestorben. Während die Todesursache einer Frau in Niedersachsen nachgewiesen ist, werden zwei weitere Todesfälle derzeit untersucht. Bundesweit steigt die Zahl der Verdachtsfälle sprunghaft an, Norddeutschland ist besonders betroffen. In Frankfurt gibt es immerhin eine erste Spur zum Ursprung.
Eine EHEC-Bakterienkultur wird im mikrobiologischen Labor des Universitaetsklinikums Eppendorf in Hamburg beschriftet.
(Foto: dapd)
Der aggressive Darmkeim EHEC hat wahrscheinlich bereits drei Frauen in Deutschland getötet. Eine 83-Jährige starb nachweislich infolge der EHEC-Erkrankung. Eine zweite Rentnerin sowie eine junge Frau litten ebenfalls vor ihrem Tod an Durchfall. Dass auch sie den gefährlichen Erreger in sich trugen, ist jedoch noch nicht bestätigt. Alle drei Frauen erkrankten in Norddeutschland.
Das zuständige Robert Koch-Institut (RKI) geht davon aus, dass es weitere Opfer geben wird. "Wir müssen auch klar sagen, dass wir mit Todesfällen rechnen müssen", sagte RKI-Präsident Reinhard Burger in Berlin. Die Infektionsquelle sei weiterhin nicht klar. Die Zahlen sind seit dem Ausbruch Mitte Mai sprunghaft angestiegen. Derzeit ist von mehr als 460 bestätigten und Verdachtsfällen die Rede.
Angesichts des sprunghaften Anstiegs der Fälle möchte sich auch der Gesundheitsausschuss des Bundestags damit befassen. Die Ausschussvorsitzende Carola Reimann sagte der "Braunschweiger Zeitung", die Abgeordneten würden sich von RKI-Präsidenten Burger über die Entwicklung unterrichten lassen. "Es gibt keinen Anlass zur Hysterie, aber dass wir es jetzt mit den ersten Todesfällen zu tun haben, erfüllt einen natürlich mit Sorge", so die SPD-Politikerin.
"Das übersteigt jedes historische Maß"
Besonders viele EHEC-Patienten registrierten die Behörden in Schleswig-Holstein. Dort sollen etwa 100 Menschen mit dem Erreger infiziert sein, noch einmal so viele Proben werden noch geprüft. "Diese Entwicklung übersteigt jedes historische Maß", sagte der Mikrobiologe Prof. Werner Solbach vom Universitätsklinikum Schleswig-Holstein.
Hamburg meldete bislang etwa 100 nachgewiesene Fälle, Nordrhein-Westfalen 24. In Bayern bestätigte das Landesgesundheitsamt 2 EHEC-Erkrankungen. In Hessen gibt es fast 30 Fälle, von denen noch nicht alle bestätigt sind. Gleiches gilt für die in Niedersachsen und Bremen gemeldeten fast 100 Fälle. Das Saarland registrierte bislang 3 EHEC-Patienten, Mecklenburg-Vorpommern geht von 15 teils noch unbestätigten Erkrankungen aus. Baden-Württemberg meldete den ersten Fall, Brandenburg den ersten Verdachtsfall.
Das RKI spricht zudem von mehr als 80 besonders schweren, sogenannten HUS-Fällen. RKI-Präsident Burger bezeichnete dies als "erschreckend viel". Das Vollbild des hämolytisch-urämischen Syndroms ist charakterisiert durch akutes Nierenversagen, Blutarmut durch den Zerfall roter Blutkörperchen und einen Mangel an Blutplättchen. In den vergangenen Jahren seien in Deutschland mehrfach Häufungen von HUS-Erkrankungen gemeldet worden, teilte die Behörde auf ihrer Internetseite mit. "Allerdings noch nie so viele Fälle in so kurzer Zeit, und noch nie mit einem Fokus auf Erwachsene."
Durchfall, Erbrechen und Übelkeit
Das besonders aggressive enterohämorrhagische Escherichia coli-Bakterium (EHEC) treibt seit Mitte Mai in Deutschland sein Unwesen. Die Erkrankung geht mit Durchfall, Erbrechen und Übelkeit einher. Der Erreger kann zu schweren, oft bleibenden Nierenschäden und zum Tod führen. Aktuell infizierten sich vor allem erwachsene Frauen in Norddeutschland.
Die massive und plötzliche Verbreitung des Keims macht die Experten weiterhin ratlos. Sie vermuten, dass ungewaschenes, mit Gülle gedüngtes Gemüse der Grund für die Ansteckung ist. "Ich wäre vorsichtig mit Rohkost oder Salat", sagte Werner Wunderle vom Gesundheitsamt in Bremen.
Die heimischen Bauern fühlen sich hingegen zu Unrecht beschuldigt. "Da wird gemutmaßt, dass EHEC-Erreger über Gülle auf das Gemüse gespritzt worden sei. Dabei ist es total abwegig, Gemüse mit Gülle zu düngen", sagte ein Sprecher der Landwirtschaftskammer Nordrhein-Westfalen in Münster. "Gülle wird nur auf Getreide-, Mais- oder Rapsäckern versprüht, aber noch bevor ausgesät wird."
Spur in Frankfurter Kantine
Bisher konnte nach RKI-Angaben noch kein konkretes Lebensmittel als Infektionsquelle identifiziert werden. Es gebe jedoch auch keine Hinweise darauf, dass rohes Fleisch oder Rohmilch die Ursache des aktuellen Ausbruchs seien.

Der Erreger könnte sich auf Gemüse befinden.
(Foto: dpa)
Licht ins Dunkel könnte jedoch eine ungewöhnliche Häufung von Fällen in Frankfurt bringen. 19 EHEC-Betroffene hatten dort in den Kantinen einer Unternehmensberatung gegessen. Schuld sei wahrscheinlich eine belastete Lieferung an die Kantinen: "Wir gehen davon aus, dass die Infektionsquelle in Norddeutschland liegt", sagte Oswald Bellinger von der Frankfurter Gesundheitsbehörde.
Die Erreger der EHEC-Infektion leben vor allem im Darm von Wiederkäuern. Bei dem derzeit grassierenden Keim handelt es sich um eine besonders aggressive Form, die zudem resistent gegen bestimmte Antibiotika sein soll. Das RKI hat seit Einführung der Meldepflicht 2001 bundesweit jährlich zwischen 800 und 1200 EHEC-Erkrankungen registriert, die aber oft einen leichteren Verlauf nahmen. Im vergangenen Jahr wurden zwei EHEC-Todesfälle gemeldet, 2009 waren es drei.
Quelle: ntv.de, dpa